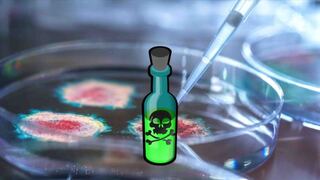

2977 videos
Documenting the New Normal
Featured playlists
These are but a sampling of the many voices who dare to question
-

PEI Flooded with Vax AR Reports -Sep 4 2023
-

Biden, A New Vaccine that Works! -Aug 28 2023
-

VAERS Massive Warning Signal Ignored by CDC! -Jul 27 2023
-

People Who Transitioned their Kids - Jul 2023
-

BBC 9-11 Broadcast Bldg. 7 -Jun 15 2023
-

Enders 1954 Control Test - The End of Germ Theory
-

Dr Cowan, The Decisive Study -Jun 7 2023
-

WHO Danger Euro MEP -May 3 2023
-

Judge Napolitano on Executive Authority -Jun 5 2020
-

FDIC Meeting, Banking Crisis -May 4 2023
-

Dr. Lawrie, Mistakes were Not made -March 2023
-

R Paul vs S Bancel, Myocarditis -Mar 22 2023
-

L Manookian, US Ppl not Complying -Mar 24 2023
-

Midazolam clown world -Mar 16 2023
-

MWGFD Symposium München -Mar 15 2023
-
Dr Cowan on Virology Fraud -Feb 10 2022
-

Prof. R Werner Experience of WEF -Jan 21 2023
-

We delivered Fraud Gov't Ordered - Mar 4 2023
-

Aaron Siri, Pharma Vax Immunity -Feb 18 2023
-

Dr Malone, Covid Shots Must Stop -Jan 30 2023
-

Dr Bailey, Gain of Function BS -Jan 8 2023
-

Vax'd to the Max for Christmas -Dec 14 2022
-

Dr. Hodkinson, The Big Kill -Dec 13 2022
-

What Goes in Your Body -Dec 22 2022
-

Call on PEI to Act -Dec 12 2022
-

Dr. Cowan Nonsense Virology -Dec 13 2022
-

NIH Conflicts of Interest -Dec 11 2022
-

RFK, All Vax Cos. Serial Felons -Dec 4 2022
-

How the Economy Works -Nov 28 2022
-

Beyond Wilful Misconduct -Dec 13 2021
-

WEF Crazy Predictions -2016
-

Post-Vac-Syndrome -Nov 18 2022
-

mRNA Diverse Adverse Consequences -Nov 14 2022
-

Massive Birthrate Reductions Vax related -Oct 29 2022
-

Cardiovascular Damage from Pfizer Shots -Sep 10 2022
-

Prof Desmet: Everyone Responsible - Aug 29 2022
-

Carl Sagan, Dangerous Direction for Society -Aug 18 2022
-

Young Canadian Dies 32 yrs old -Aug 16 2022
-

Subverting VAERS Danger Signals -Sep 17 2021
-

Dr Sam White, Met Case Aftermath -5 Aug 2022
-

Resist EU digital identity -Aug 7 2022
-

Resist the Digital Financial Complex -Aug 1 2022
-

Mark Steyn Vaccine Review -Jul 25 2022
-

Germans struggle: energy crisis - July 2 2022
-

Russia's POV on Ukraine 'Invasion' -Jun 20 2022
-

CH Lawyer Appeal to Public -Jun 7 2022
-

Royce A White "Hijacking the Narrative" -May 27 2022
-

M Chossudovsky, China's Role in Corona -May 20 2022
-

M Chossudovsky, Liquidation of SMEs -May 20 2022
-

GB News Vaccine Victim -May 11 2022
-

Vax Widow Charlotte Pt. 2 -May 5 2022
-

Vax Widow Charlotte Pt. 1 -May 5 2022
-

The forgotten dead -May 5 2022
-

Vax Widow Vikki Pt. 2 -May 5 2022
-

Prof. Miller 1. Propaganda History - Apr 29 2022
-

CA Medical Misinformation Bill -Apr 26 2022
-

Pfizer Not-so-Secrets Now -Apr 26 2022
-

Vax Makers are Serial Felons -Apr 17 2022
-

Vax Injuries Down Under -Apr 10 2022
-

Australia Digital Slavery -Feb 11 2022
-

Decoded, The Bilderberg Group -Mar 27 2022
-

The Viral Delusion -March 2022
-

War & Fake Pandemic for Profit -Mar 15 2022
-

Riccardo Bosi on Ukraine Crisis -Mar 16 2022
-

E Dowd on Excess Deaths -Mar 10 2022
-

Vaccine Approval Nonsense -Feb 25 2022
-

Dr Hodkinson Vax Kills -Feb 23 2022
-

Israeli freedom camp eviction-Feb 21 2022
-

Global Health Monster WHO -Feb 20 2022
-

Champs Elysées -Feb 12 2022
-

Ottawa Police Action 5 -Feb 18 2022
-

Ottawa Police Action 4 -Feb 18 2022
-

Ottawa Police Action 3 -Feb 18 2022
-

Ottawa Police Action 2 -Feb 18 2022
-

Ottawa Police Clearing Action 1 -Feb 18 2022
-

Macron Put in Place - Jan 22 2022
-

Europe Compilation, Freedom Day -Jan 23 2022
-

Watch The Sneaky Bastards -Jan 20 2022
-

Citizen's Action at UK Vax centre -Jan 15 2022
-

J Peterson - Time to Live Again -Jan 13 2022
-

Peterson, Time to Live Again Pt. 2 -Jan 13 2022
-

Heart Attack on Pitch -Jan 8 2022
-

Global People's Revolution! 11/12 Dec 2021
-

Hello Pfizer We are Real - Dec 12 2021
-

Rule of Law is Essential -Dec 10 2021
-

FIRST, Stop Digital Pass -Dec 10 2021
-

Vaccine Pass? a Control Grid -Dec 10 2021
-

There are No Governments! -Dec 10 2021
-

C-19 Vax. w/o Data, it's not Science -Nov 2 2021
-

Protecting Patients from Harms -Nov 2 2021
-

Kyrie Irving no vax, no play - Oct 14 2021
-

Police Vax Mandate Dropped -Feb 27 2024
-

Virus Existence D Rancourt -Feb 1 2024
-

Vax Deaths Correlation - Dec 7 2023
-

War on Gaza -Oct 16 2023
-

Deaths from Medical Malpractice -Sep 25 2023
-

Prof Fukushima Vaccine Genocide -Sept 7 2023
-

A Bridgen on GBNews, Midazolam deaths -Sep 17 2023
-

Pfizer President Serial Liar -Aug 10 2023
-

9/11 Conspiracy Explained -Feb 29 2020
-

If We Do a Good Job - Aug 3 2023
-

Modified RNA Genocide -Sept 6 2023
-

SPARS Pandemic Programming 21017 -Aug 30 2023
-

Trump, No to Covid Tyranny -Aug 31 2023
-

Eric Clapton, Extreme Covid Propaganda -Aug 23 2023
-

John O'Looney, A Heavy Load -21 Aug 2023
-

Vaccine Aluminium to the Brain? - Aug 22 2023
-

Covid Compliance Test -Aug 15 2023
-

Remove Indemnity for Pharma Cos. -Aug 10 2023
-

Vax'd vs Unvax'd Kids Study -Sep 9 2022
-

Midazolam Murder of Elderly -Aug 10 2023
-

Aussie Gov't Forced Vaccination -Aug 8 2023
-

Talk TV, Illegal Transgender indoctrination -Jul 29 2023
-

Dr Binder, Greatest Ever Medical Crime -Aug 4 2023
-

Ice Cube No Vax -Jul 26 2023
-

Testimony Vaccination Coercion at EU Parliament -Jul 4 2023
-

Mark Sexton , UK High Court Review -Jun 12 2023
-

If I was the Devil - Jul 17 2023
-

Vaccine Death Results Too Much to Bear! -Jul 11 2023
-

Israel Vaccine Report, No New Signals -Oct 2022
-

Israel Vax Research Team Warning -Sep 1 2022
-

Workplace Wokeness Reality - Jun 16 2023
-

James O'Keefe Blackrock - June 2023
-

Weather Engineering Experiments -Jun 23 2023
-

Ghislaine Lanctot on 'Vaccination' -Dec 16 2020
-

The End of Covid -Jun 2023
-

Prof Burkhardt, Damage from Spikes or LNPs -May 5 2023
-

Carbon Dioxide is Not Your Enemy -May 31 2023
-

Canadian Citizens Covid-19 Enquiry -Jun 1 2023
-

Dr Cowan, Are SP Methods specific? -Jun 7 2023
-

Nordstream Whodunnit, Part 2 -May 5 2023
-

A Siri, Dr. Stanley Plotkin's Vaccines -May 25 2023
-

A Siri, Kid's VAX Untested & Unsafe -May 25 2023
-

A Siri, Vax Manufacturer's Immunity -May 25 2023
-

A Siri, Market Regulation of Vax. Safety? -May 25 2023
-

Italy PM Announces Lockdown -Mar 2020
-

USA 15 days to 'Slow the Spread' -March 2020
-

Farmer's Land Confiscated for CO2 Capture -Nov 9 2021
-

Judge Napolitano and Vax Mandates-Jun 5 2020
-

THE UNVACCINATED are a Risk to All of Us -May 21 2023
-

THE UNVACCINATED Nobody is Safe! -May 21 2023
-

Prof. Sucharit Bhakdi Trial Video -Sep 24 2021
-

Prof. Sucharit Bhakdi Trial -May 23 2023
-

Dutch Farmers, Shut Down -Apr 2023
-

Wayne Cunnington at Truth be Told -May
-

Jessica Rose at EP Covid Summit -May 3 2023
-

WHO Treaty, Kirsch & Latypova -May 11 2023
-

How Funding Influences Data -May 11 2023
-

The Real 'Inconvenient Truth' -Jun 6 2022
-

Unvaccinated Scum -May 12 2023
-

Who defines truth? - May 17 2023
-

Ed Dowd, Human Costs of Jabs -May 14 2023
-

Trial of Prof. Bhakdi, Political Trial?-May 14 2023
-

Ukraine Cocaine -May 13 2023
-

Six Million Variants of Nothing -May 10 2021
-

"We Are Ready", May 20 2023 -May 8 2023
-

Climate Change Scientifically Demonstrated -May 6 2023
-

Prosecution for Murder -May 6 2023
-

(For Your) Safety Dance -May 15 2022
-

Mises The Great Reset, 7. Refusal Plan -May 1 2023
-

Mother's Testimony, Vax Victim -May 2 2023
-

“They Didn’t Isolate The Virus” -Jan 27 2021
-

1934 Depopulation Cartoon -May 5 2023
-

Texas State Investigation of Pfizer, Moderna & J&J -May 3 2023
-

Mises The Great Reset, 6. PPPs -May 1 2023
-

Mises The Great Reset, 5. Corporate Socialism -May 1 2023
-

Mises The Great Reset, 1. Background -May 1 2023
-

Australian Class Action Lawsuit, Pt 2 -May 2 2023
-

Australian Class Action, Vax Injuries Pt 1 -May 2 2023
-

US Gov ends Vax Mandate for Travellers -May 2 2023
-

Who Checks Fact-Checkers? -May 5 2023
-

STIKO About Turn -Apr 29 2023
-

Nordstream 2 Whodunnit Revisited -Apr 28 2023
-

Cancel Culture, Trudeau Impersonator -Apr 27 2023
-

A Bridgen, Unaccountable WHO & 3Ps -Apr 17 2023
-

Esther McVey, WHO Treaty Petition -Apr 17 2023
-

A Bridgen Cancelled by Conservatives -Apr 27 2023
-

WHO 500 New Vaccines! -Apr 25 2023
-

Justin Trudeau Vax Mandate Lies -Apr 24 2023
-

T Carlson on US Media Lies/ Propaganda -Apr 19 2023
-

Bundestag Rejects Corona Investigation! -Apr 21 2023
-

Ukraine to be like Israel -Apr 19 2023
-

15 minute cities UK -Apr 18 2023
-

RFK Jr 'Socialism for the Rich'
-

Common Sense, UK Column -Apr 19 2023
-

mRNA (Speed of Science) -Feb 4 2023
-

The Spike Protein Fairy Story Pt 1 -Apr 15 2023
-

Invisible Fences Docu Trailer -March 2023
-

History of Virology pt. 4-Virus Isolation -Mar 9 2023
-

History of Virology pt. 3-Looking for the Virus 1908-1954 -Mar 9 2023
-

History of Virology pt. 2-Virus Beginnings -Mar 9 2023
-

History of Virology pt. 1-Transmission -Mar 9 2023
-

Mistakes Were NOT Made - Mar 18 2023
-

MHRA Expected Adverse Events -Apr 5 2023
-

C Anderson vs Emer Cooke -Apr 3 2023
-

Hodkinson -20MM dead from 'Clot Shots' -31 Mar 2023
-

Yeadon, Resist Totalitarian Tyranny - Mar 28 2023
-

L Manookian HFDF Case Wins -Mar 24 2023
-

Renz Law, Hospital Whistleblower -Mar 23 2023
-

FL Surgeon General: Vax Not Safe - Mar 16 2023
-

What's in Vaccines Pt. 2 Foetals Cells -Jan 11 2018
-

Vaccine Ingredients Pt. 1 -Jan 11 2018
-

MEP, C-19 Vaccines Incinerated -Mar 16 2023
-

Letter to Jacinda Ardern -Mar 2 2023
-

Dr Cowan, Virus 'sequencing' -Feb 10 2022
-

Lying Health Minister, Lauterbach -Mar 12 2023
-

Prof. Sönnichsen, Useless & Dangerous Vax -Mar 11 2023
-

Tom Renz Rant -Mar 7 2023
-

UK Hotel Owner, Migrant Crisis -Mar 6 2023
-

Prof Karol Sikora on the Lockdown Files -Mar 5 2023
-

David Starkey, Government by Lies -Mar 5 2023
-

Prof. Heneghan, The Lockdown Files -Mar 5 2023
-

Gates' "final solution" - Jan 24 2021
-

Reduce Worlds Population Dream Becoming Reality - Jan 20 2023
-

Make a Billion Dollars on upcoming pandemic - Feb 8 2023
-

We delivered Fraud Gov't Ordered - Mar 4 2023
-

Corona ATROCITIES, Midazolam Murders -Mar 1 2023
-

Dr Fauci, Use of Lockdowns -Feb 27 2023
-

Vaccine Fertility Disaster -Feb 25 2023
-

SwissMedic Case, Next Steps -Jan 22 2023
-

Kruse, Working at the Speed of Thought! -Jan 22 2023
-

Kruse, Why SwissMedic and not Pfizer? -Jan 22 2023
-

Kruse, Most Restrictive CH Measures -Jan 22 2023
-

P. Kruse, Principle of Proportionality -Jan 22 2023
-

Prof Burkhardt "If I were a woman ..." -Feb 11 2023
-

Idaho Making mRNA Illegal -Feb 20 2022
-

Pfizer Vaccine Lies -Feb 19 2023
-

Nordstream Sabotage Whodunnit? -Feb 2023
-

French Doctor Sends SOS -Feb 5 2023
-

Dr Sönnichsen, No Pandemic Emergency -Feb 10 2023
-

Austrian Vaccination 'Fraud' Case -Feb 10 2023
-

Censuring Twitter Censor -Feb 9 2023
-

Gates Behind The Bars- Feb 6 2023
-

Dr John Campbell, Moments of Truth -Feb 5 2023
-

Dr John, Excess Deaths 'We want answers' -Feb 5 2023
-

Dr Malhotra, Conspiracy Theorist? -Jan 31 2023
-

German Mask Police, Winter fun -2021
-

OTA Military Sourcing of Pfizer Shots -Jan 28 2023
-

Prof Bhakdi, mRNA Package is Deadly -Jan 28 2023
-

Retsef Levi, Stop m-RNA -Jan 30 2023
-

Greatest Medical Crime Ever! -Jan 25 2023
-

Naomi Wolf, Massive Birthrate Declines -Jan 23 2023
-

Karl Lauterbach, Climate Lockdowns -Jan 29 2023
-

Vax Victim Cruelly Mocked -Jan 28 2023
-

CDC V-Safe Data Release -Nov 2022
-

Variants Don't Exist -Jan 9 2023
-

Seasonal Nature of Illness -Jan 13 2023
-

Virologist's Magic Tricks -Jan 13 2023
-

How To Be Healthy -Jan 13 2023
-

The Contagion Myth -Jan 13 2023
-

Why People Get Sick -Jan 13 2023
-

The PCR Diagnostic Myth -Jan 13 2023
-

Berlin Undertaker XS Deaths Pt.1 -Jan 20 2022
-

Bourla, Time to Come Clean -Jan 20 2023
-

Pfizer CEO put On The Spot -Jan 18 2023
-

E Ramirez, How Low Can They Sink? -Jan 13 2023
-

Dr J Wallskog Vaccine Injured -Jan 18 2023
-

A Pandemic of Testing -Jan 8 2023
-

Dr Malone, Out WEF YGL's -Jan 14 2023
-

Salisbury Cathedral Mass Vax Centre -Jan 14 2021
-

Dr. Malhotra on BBC on Vax Harms -Jan 13 2023
-

McCullough Vaccine Deaths -Jan 10 2022
-

Coincidence is Leading COD -Jan 11 2023
-

Dr Shapira, Wrong to take Vax -Dec 21 2022
-

Withdraw the m-RNA Vaccines -Jan 9 2023
-

P Najadi Criminal Complaint Pt. 1 -Dec 2022
-

Tedros, Spreading Death Equitably -Dec 26 2022
-

Never Forget What They Said -Sep 15 2022
-

Bill n' Bourla, Moving On -Sep 15 2022
-

It's All a Pack of Lies! -Dec 26 2021
-

UK Docs, Stop the Shots Pt 1 -Dec 12 2022
-

Call on PEI to Act -Dec 12 2022
-

Denmark & mRNA Vaccines -Dec 13 2022
-

Mass Murder by Pfizer -Dec 29 2022
-

The People vs Globalist Elite -Dec 28 2022
-

Dr. Thomas Binder's Arrest -Sep 11 2022
-

Sen. Ron Johnson on 'the vaccine' -Dec 2022
-

11 yr Old on Corona, Part 2 -Aug 8 2022
-

11 Yr Old on Corona Nonsense Pt 1 -Aug 8 2022
-

CDC Cherry Picking AR Data -Dec 7 2022
-

Shot to the Heart -Dec 17 2022
-

Germany Vaccination Consequences -Dec 12 2022
-

Vaccine Injuries in Australia -Dec 6 2022
-

Amish Covid - Jan 17 2022
-

Vax Victims are 'Ghosts' -Dec 7 2022
-

Bonhoeffer, Theory of Stupidity -Oct 15 2021
-

UK Vax'd dying at Higher Rates! -Dec 7 2022
-

Pilots vs. Quantas Mandates -Dec 9 2022
-

Quantas Pilot Speaks Out -Dec 9 2022
-

Hold m-RNA Manufacturers Accountable -Dec 7 2022
-

m-RNA Cancer Booster! -Dec 4 2022
-

NZ Vax'd Blood Case -Dec 6 2022
-

Vax Causes Cardiac Failures -Oct 19 2022
-

Prof Fukushima- Stop Vax! -Nov 29 2022
-

Jap. Prof. Slams Vaccines -Nov 29 2022
-

Idaho Embalmer Speaks Out -Sep 26 2022
-

A. Burkhardt on Aortic Dissection -Sep 18 2022
-

Dying Later from the V@x -Nov 21 2022
-

US VAERS Signal Ignored -Nov 21 2022
-

The Labelling of Steve Kirsch -Nov 21 2022
-

Globalist Elite Agendas -Nov 21 2022
-

US Army Lt. Col Whistleblower -Nov 21 2022
-

Embalmers Speak Out -Nov 21 2022
-

Mass Vaccine Clinical Trial! -Nov 20 2022
-

Vaccine-The Movie -Nov 19 2022
-

Mass Asset Grab by Super Rich -Nov 15 2022
-

Swissmedic Criminal Negligence Complaint -Nov 14 2022
-

Crazy Climate 10 Commandments -Nov 11 2022
-

No Spike Proteins, Just Toxic LNPs -Nov 3 2022
-

Vaccine Induced Brain Damage -18 Sep 2022
-

Prof. Burkhardt, Vax Induced Autoimmune Disease -Sep 18 2022
-

C Anderson "House of Cards is Tumbling" -Nov 7 2022
-

ICONIC Woke Gender Nonsense -Oct 15 2022
-

ICONIC Sustainable Dev. Trojan Horse -Oct 15 2022
-

ICONIC NWO Role of United Nations -Oct 15 2022
-

ICONIC Implementation Agenda 2030 -Oct 15 2022
-

ICONIC NWO Predictive Programming - Oct 15 2022
-

US Vax'd vs Unvax'd Conclusions - Oct 21 2022
-

US Vaccinated vs Unvaccinated Study - Oct 21 2022
-

Lauterbach Palm off, Post-Vac-Syndrome -Sept 2022
-

Von der Leyen Called to Resign -Oct 19 2022
-

Pfizer Moved "At the Speed of Science" -Oct 12 2022
-

Illusion of EU Democracy -Oct 11 2022
-

Pfizer Vaccine Fraud, Pt.1 -Oct 10 2022
-

Pfizer Vaccine Fraud, Pt.2 -Oct 11 2022
-

Prosecuting Vaccine Fraud -Oct 7 2022
-

MEP Rob Roos, vaccine lies -Oct 11 2022
-

We Don't Need You! -Oct 8 2022
-

Climate Change not due to C02 -Sep 9 2022
-

It's a SADS World -Sep 4 2022
-

Sharav "It's the Entire Human Family" -Sep 2 2022
-

Legal Claims Against EU Vax Regulator -Sep 2 2022
-

Resist or "Never Again" is Now -Aug 20 2022
-

Sen Malcolm Robert - It is all BS - Aug 26 2022
-

Right to Fly Under Attack -23 Aug 2022
-

US Air Force Vax Injury Cover-Up -Nov 2 2021
-

Digital-Financial Complex -Aug 21 2022
-

Fauci Gaslighting Us Again - Aug 26 2022
-

Pfizer's Attempt to Conceal Safety Data - July 11 2022
-

Sudden adult death syndrome - Aug 23 2022
-

"We're Fed UP!" -May 2022
-

How to make a Successful Vaccine -Aug 15, 2022
-

Broken Bargain with Pfizer -Aug 13 2022
-

Pfizer Could be Bankrupted by this Lawsuit -Aug 13 2022
-

"They'll Come After You if you Go Public" -Aug 13 2022
-

False Claims Act Lawsuit Filing -Aug 13 2022
-

Federal Gov. Revealed Jackson's Identity to Pfizer -Aug 13 2022
-

For Pfizer it was First to Market -Aug 13 2022
-

Why Were Ventavia Rushing the Trial? -Aug 13 2022
-

B Jackson, Ventavia Unblinded Randomised Trial Participants -Aug 13 2021
-

Nurse Regrets Taking Vax -Aug 7 2022
-

A Tale of Two Prisoners -Aug 5 2022
-

Shocking Pfizer Fraud Kids Vaccine Trial -Aug 8 2022
-

Is the WEF Playing God? -Aug 3 2022
-

Forbidden Knowledge with Vicky Spit -Jul 17 2022
-

Alberta Leading COD Unknown! -Jul 25 2022
-

Pastor Pawlowski Legal Win-Jul 24 2022
-

Wokism confronts Sen. Hawley - Jul 14 2022
-

MonkeyPox Summit: Christine Massey -Jul 20 2022
-

Illegal Dutch Romeo Police-Jul 14 2022
-

You will Never be Fully Vaxed!-Jul 14 2022
-

MonkeyPox Summit - Amandha Vollmer -Jul 14 2022
-

MonkeyPox Summit - -Jul 14 2022
-

FDA Committing Genocide - June 22 2022
-

Birx Admits, Guessing & Hoping - Jun 24 2022
-

Fakestream 🤡 Media Heart 💝 Compilation-July 4 2022
-

Gates & Mordor Food Supply - July 9 2022
-

"I Choose Freedom" -Jun 29 2022
-

EU Commission Green Pass -Jun 22 2022
-

T Lausen on Army Vaccine Hearing -Jun 8 2022
-

Leipzig Court Hearing Summary -Jun 19 2022
-

Trouble for Trudeau -Jun 20 2022
-

Scandal at the Paul Ehrlich Institute -Jun 14 2022
-

Prof Clancy: Covid-19 Narrative - Jun 4 2022
-

The Plan of WHO -May 4 2022
-

California Illegally Censors Doctors -Jun 1 2022
-

Vaccine Damage Nightmare UK -May 12 2022
-

Pfizer Jab only a 'Prototype'! -May 21 2022
-

Davos Day 3: Chasing Globalists - May 25 2022
-

Dr M Trozzi's Story Pt. 2 -May 13 2022
-

Naomi Wolf on the Vaccines 1 -May 13 2022
-

You Will Not Get Away With It -May 13 2022
-

MEP says We're Surrounded by Psychopaths -May 11 2022
-

Million March in Frankfurt -Jun 25 2022
-

Lawyer B Bahner Vax Injury Update -May 9 2022
-

Rand Paul Against Mandates -Nov 3 2021
-

India Supreme Court Landmark -May 3 2022
-

Vax Effect on Reproduction Israel Pt.2 -May 6 2022
-

Vax Effect on Reproduction Israel Pt.1 -May 6 2022
-

India Legal Situation Summary -Apr 22 2022
-

Dr Külken, Body & Mind Medicine -Apr 22 2022
-

Israel Deaths Post Vaccination -Apr 22 2022
-

Prof Miller 6. Defamation of Doctors / Journalists -Apr 29 2022
-

Prof. Miller 5. Mainstream Media Conspiracy? - Apr 29 2022
-

Prof. Miller 4. Sudden Death 'Normalisation' -Apr 29 2022
-

Prof. Miller 3. Documenting Global Democide -Apr 29 2022
-

Prof. Miller, 2. Who is Behind Propaganda? - Apr 29 2022
-

Time for Unpleasant Questions -Apr 26 2022
-

7 Ways Hospitals Profit from Covid -Mar 8 2022
-

Why Masks Don't Work, Pt 2 -Apr 5 2022
-

Why Masks Don't Work Pt. 1 -Apr 5 2022
-

NWO USA Opens Borders -Apr 19 2022
-

CDC Fact Checks mRNA - Mar 24 2022
-

CORONA IST VORBEI -Apr 9 2022
-

War on Human spirit -Apr 9 2022
-

10 Major Corona Facts -Mar 11 2022
-

Tenpenny: Cancer Explosion - Mar 29 2022
-

Zelenko: Guilty Should be Executed - Apr 6 2022
-

'Northern Territory Mandates Invalid-Apr 2 2022
-

Roberts: We are coming Pt. 2 -Mar 30 2022
-

Roberts: We're coming Pt. 1 -Mar 30 2022
-

UK Gov. Media CONTROL -Mar 23 2022
-

Mr Trudeau, You Are a Disgrace -Mar 23 2022
-

Creating a 'Successful Pandemic' -Feb 4 2022
-

BBC World Propaganda Exposed -Feb 8 2022
-

Covid Vax Death is Suicide -Mar 18 2022
-

Lawyer Bahner Unsafe Vaccines -Mar 14 2022
-

LQColumna GO Update Pt. 2 -Mar 6 2022
-

LQColumna GO Update Pt 1. -Mar 6 2022
-

I Bought Myself A Politician - Aug 28 2021
-

Putin on Russian Security Needs -Mar 2 2022
-

KS Warns of Vax Dangers Pt. 2 -Mar 2 2022
-

Kay S Warns Vax Dangers Pt. 1 -Mar 2 2022
-

The Disease is not Existing -Sept 2 2020
-

Jordan Peterson: Wake Up - Feb 19 2022
-

Blood Vessel Vax Damage -Feb 20 2022
-

German TV Crisis Actor - Feb 17 2022
-

Nobel Prize Winner Montagnier-Feb 19 2022
-

TV Fainting Post Vax! -Feb 14 2022
-

Min. 1.4 million Freedom Rally in Canberra! -Feb 12 2022
-

Grand Jury Judge, Rui Castro -Feb 5 2022
-

Grand Jury Attorney N A Garner -Feb 5 2022
-

Dr Hodkinson Ottawa Speech -Jan 30 2022
-

Canada Freedom Convoy -Jan 25 2022
-

Needle & Damage Done - Jan 14 2022
-

Student's Mock Thank You - Jan 22 2022
-

Vaccine Expert Statement Pt. II -Jan 20 2022
-

Expert Vaccine Statement Part I - Jan 20 2022
-

Jesus...What Happened to Us? - Oct 14 2021
-

Legal Action Houston Methodist - Jan 20 2022
-

Come to Brussels Jan 23 - Jan 19 2022
-

UK Crime #6029679/21 -Jan 18 2021
-

Dr. White Masking Kids -Jan 17 2022
-

Frankfurt for Freedom -Jan 8 2022
-

French Students Revolution -Jan 14 2022
-

Riccardo Bosi Australia News -Jan 14 2022
-

Parents Ask Why Hiding Data - Jan 12 2022
-

Nurse Testimony: Ticking Timebomb -Jan 10 2022
-

Veritas: Gain of Function -Jan 10 2022
-

NY Nurse COVID Insanity - Jan 9 2022
-

BBC employee dies of Vax - Jan 4 2022
-

Fuellmich: Vax Batch Toxicity -Dec 31 2021
-

Dr White Analysis Repeatability -Dec 31 2021
-

Dr White, Mass Medical Experiment -Dec 31 2021
-

Dr. White, Premeditated Harm -Dec 31 2021
-

When Premeditation, No Immunity -Dec 31 2021
-

Bahner Vaccine Warning -Dec 19 2021
-

unvaxxed denied farmers market - Dec 29 2021
-

Candace Owens Truth Bombs - Dec 29 2021
-

New York Bill A416 - Dec 30 2021
-

Unfortunate Coincidences! -Dec 26 2021
-

Tiffany D -Dead or Alive? -Dec 17 2021
-

Confused Vaccinating Doctor -Dec 24 2021
-

Looks like Genocide! -Dec 25 2021
-

UK Int'l. Criminal Court case -Dec 24th 2021
-

The 12 doses of Christmas -Dec 24 2021
-

Pfizer Media Capture -Dec 16 2021
-

Pfizer -Phama / CDC Connivance -Dec 16 2021
-

Pfizer's conflicts of Interest -Dec 16 2021
-

FDA Forced to Release Pfizer Report -Dec 16 2021
-

Pfizer Trial Proves Harms -Dec 16 2021
-

Young People Dropping from Pfizer -Dec 16 2021
-

Pfizer Whistleblower BMJ Expose -Dec 16 2021
-

Pfizer Kids All Risk No Benefit -Dec16 2021
-

Pfizer Wrong Clinical End Point -Dec 16 2021
-

Pfizer's Failure to Use Disease Biomarkers -Dec 16 2021
-

Pfizer Didn't Follow Protocols -Dec 16 2021
-

Pfizer Unblinding of Clinical -Dec 16 2021
-

Pfizer Vax <1% Effective -Dec 16 2021
-

Naughty Boy Boris' Party -Dec 15 2021
-

This Thing is a TRAP! -Nov 12 2020
-

Beginning To Look At Lot Like Fascism - Dec 13 2021
-

This Won't Do for British - Dec 13 2021
-

Mask Kindergarten Rail Station -Dec 2 2021
-

Global Revolution Not on TV -Dec 2021
-

Finding Out the Hard Way -Dec 10 2021
-

PCR Can't Diagnose Anything -Dec 7 2021
-

Vaccines Don't Save Lives -Dec 4 2021
-

Social Pressure to Conform - Dec 7 2021
-

AFLD Kaiser Lawsuit -Dec 7 2021
-

No Corona for the Rich! -Dec 5 2021
-

Dr. Sam White vs the NHS - July 5 2021
-

Dr. S White Free Speech Win -Dec 3 2021
-

Siracusa Principles of Human Rights -Dec 1 2021
-

It's Just A... - Dec 2 2021
-

Build Back Britain -May 13 2021
-

What's Going On? V2 - Nov 28 2021
-

RFK Jr-Exposing Social Media Tyranny - Nov 20 2021
-

Nurse: Hospitals Overwhelmed by Vaxx Injuries - Nov 25 2021
-

Arrest The Management! -Nov 26 2021
-

Kim Witczak, Drug Safety Advocate -Nov 2 2021
-

MEP Conference, Question 2 -Nov 24 2021
-

Mask Child Abuse - Oct 31 2021
-

Australian Aboriginal Need Help - Nov 25 2021
-

MEPs Human Rights Violations 4 -Nov 24 2021
-

MEP's Human Rights Violations 3 -Nov 24 2021
-

MEPs Human Rights Violations 2 -Nov 24 2021
-

MEPs Human Rights Violations 1 -Nov 24 2021
-

Dr Coleman Evidence Jabs Must Stop -Nov 24 2021
-

Gr. Guido Hoffmann -Oct 14 2020
-

Aborigines Forced Jabbing -Nov 24 2021
-

CA Fitts Swiss Referendum -Nov 24 2021
-

Prof. Bhagdi, Swiss Referendum -Nov 24 2021
-

Gibraltar Cancels Christmas -Nov18 2021
-

D Cameron Farm Ops. Mgr -Nov 2 2021
-

RFK Milan, Vaccine Maths -Nov 13 2021
-

RFK Jnr. Fact Check Me -Nov 12 2021
-

HC Workers vs Mandates 2 -Nov 12 2021
-

HC Workers vs Mandates 1 -Nov 12 2021
-

Vaccinate Me Doll -Nov 10 2021
-

Pfizer Whistleblower Report -Nov 5 2021
-

Athletes Injuries & Deaths - Nov 7 2021
-

Pilot Vaccine Victim -Nov 2 2021
-

Prof. Retsef Levi Pt. 2 -Nov 2 2021
-

Prof. Retsef Levi Pt.1 -Nov 2 2021
-

US Nurse's Vaccine Injuries Pt. 2 -Nov 2 2021
-

US Nurse's Vaccine Injuries Pt. 1 -Nov 2 2021
-

Vaccine Maimed Surgeon -Nov 2 2021
-

Mandates Open Door to Tyranny! -Nov 2 2021
-

Kellai Rodriguez, Mother -Nov 2 2021
-

Former Active Biker/Tri-Athlete -Nov 2 2021
-

US Gov. Lied to Me -Nov 2 2021
-

Pfizer Vaccine Terrorism -Nov 1 2021
-

I Consider It Murder -Nov 1 2021
-

Dr Jensen's Spanish Inquisition -Oct 26 2021
-

Vax Risks, Unknowns, Questions -Jul 21 2021
-

Safe, Effective & No Alternatives? -Jul 21 2021
-

Getting Vaccinated? -Jul 21 2021
-

Theory of Stupidity -Oct 15 2021
-

Highly Effective Fauci! - Oct 21 2021
-

Classic David Icke -Aug 29 2020
-

R Bosi -Take Back Australia -Oct 26 2021
-

MEPs Anti Vax Mandates #2 -Oct 23 2021
-

MEPs Anti Vax Mandates #1 -Oct 23 2021
-

Let's Go Brandon -Oct 20 2021
-

5 Facts to End Pandemic -Sep 17 2021
-

Israel gov. deletes vax AR reports - Oct 10 2021
-

Controlled, manipulated & lied to -Oct 9 2021
-

Pfizer scientists talk 'off the record' - Oct 3 2021
-

R Paul battles Sec. Becerra -Sep 30 2021
-

Dead bodies don't lie - Oct 1 2021
-

Covid Vaccine Victims - Sep 12 2021
-

Hello Darkness My Old Friend -Sep 28 2021
-

Australia One - Freedom party message - Sep 16 2021
-

Ret'd PC M Sexton vax update - Sep 22 2021
-

Al nanoparticles ex vax cause brain injury - Sep 23 2021
-

Pandemic Nonsense with Dr. Thomas Binder - May 8 2021
-

New Jersey Hospital Whistleblower - Sept 5 2021
-

Professor's last ethics lesson -Sep 7 2021
-

Eric Clapton - This Has Gotta Stop (Official Music Video)
-

Sorry Time for the Weather -Aug 14 2021
-

Israel vs Palestinian Data -Aug 10 2021
-

Nurse Threatened, Coerced & Fired -Aug 10 2021
-

Prof Desmet Crisis & Anxiety -July 30 2021
-

Chris Sky at Montreal Protest -Aug 18 2021
-

School Nurse Resigns -Aug 18 2021
-

Ernst Wolf on Digital Currency & UBI -Aug 13 2021
-

Senate: We Are Guinea Pigs - Aug 16 2021
-

No freedom in NSW - Aug 17 2021
-

LUKAS LION "1984" -Aug 14 2021
-

Crime against Children -July 09 201
-

CDC Unelected Head of State? -July 28 2021
-

Meet the Vax Injured -July 29 2021
-

Nurse on Vax Injuries & Deaths -July 29 2021
-

America's Frontline Doctors "Enough is Enough" -July 27 2021
-

Inventor mRNA Vaccines &Safety -Jul 26 2021
-

France Hospital Staff Strikes -July 24 2021
-

"We Don't Know Anything" -July 23 2021
-

18000 Vax Deaths in EU -July 17 2021
-

Who Dies from Covid? -July 7 2021
-

US Lawyers on Mask Lawsuit -July 17 2021
-

Masks Also for Vaccinated -July 17 2021
-

France Anti Macron Protest -July 17 2021
-

What Happened To Me After Vax -July 17 2021
-

Vaccine Truths -July 8 2021
-

Vaccine Dictatorship -July 8 2021
-

"Accidental" Vaccination of 163 Kids -July 7 2021
-

French MSM wants Medical Tyranny -July 8 2021
-

Texas Normal -June 30 2021
-

"We Should Look in the Mirror" -June 30 2021
-

12-Year-old Maddie After the Vaccine -June 29 2021
-

Francis Hoar on London Protest "The Awakening" -June 28 2021
-

Mistrust of Government is Growing -June 30 2021
-

PCR Test Results Explained -June 28 2021
-

Doctor of Neurology on Vaccine Injuries -June 28 2021
-

Bret Weinstein on Big Tech & Big Pharma -June 30 2021
-

New! JAMA Study on Mask Dangers -July 1 2021
-

"Make Mine Freedom" part 1 -1948
-

The Slippery Slope Towards Slavery - June 28 2021
-

Reiner Fuellmich on vaxxed airline pilots - June 25 2021
-

Covid Hypocrites -Jan 26 2021
-

Animal Vaccine Testing & Results -June 11 2021
-

UK Health Adviser Wants Permanent New Normal -June 11 2021
-

15 States Prohibit Vax Passports -June 9 2021
-

India Police Give Badges Separating Vaxed & Unvaxed -June 9 2021
-

Senator Rand "Fauci Lied" -June 9 2021
-

“When You Attack Dr Fauci, you're Attacking Science” -June 10 2021
-

Hospital Busy with Vax Injuries -June 9 2021
-

Nurse Bullied By Hospital & Government Lies -June 9 2021
-

How Dangerous is Covid? -May 20 2021
-

Dr Hodkinson "State Sanctioned Child Abuse" - June 11 2021
-

Ano Turtiainen MP on Vaccine Crime -June 16 2021
-

Dr Bartlett "No Covid Patients, Only Vax Adverse Reactions" -June 6 2021
-

My Mother Died From Moderna Vaccine -June 6 2021
-

What is in the Vaccine? -May 20 2021
-

Death Graphs Post Vaccine -Apr 22 2021
-

Cruise Liner Will Not Vaccine Discriminate -June 4 2021
-

Dutch Politician Thierry Baudet on Lockdown Nonsense -June 4 2021
-

Doctor Quits over Lockdown Lies -June 4 2021
-

"Vaccine is Individual Choice" -June 4 2021
-

Dr Yeadon "Asymptomatic" Transmission Facts & Lies -June 4 2021
-

Dr Jensen on Fauci’s Emails & Deceits -June 3 2021
-

Dr Kendrick "Half of Excess Deaths are Result of Lockdown" –Mar 8 2021
-

Government's Changing Position On Vaccine Passports –Mar 19 2021
-

French Paramedic - Massive Increase in Deaths & Jab - June 3 2021
-

In this State, Masks are Un-Constitutional -June 1 2021
-

Netanyahu Wants to MICROCHIP Kids -June 3 2021
-

Boris Johnson Wants World Wide Total Surveillance -May 31 2021
-

Rand Paul on Vaccine Logic & Mandates -May 28 2021
-

Bill Nye "If You Wear One Of These Your Protected" -May 27 2021
-

Dr Köhnlein "Ask the Undertakers" -Oct 27 2020Dr Köhnlein "Ask the Undertakers" -Oct 27 2020
-

Dr Köhnlein "Wrong Way To Fight Viruses" -Oct 27 2020
-

Australian Senator says NO to Mandated Vaccines -May 26 2021
-

Vaccine & Heart Problems -May 25 2021
-

Mattie McGrath Challenges Green Passports -May 25 2021
-

Dr Köhnlein "The whole thing is a PCR Pandemic" -Oct 27 2020
-

Most Africans Refusing Vaccine -May 24 2021
-

Kary Mullis Wanted To Unmask Fauci -May 23 2021
-

NHS Nurse Kirsty Miller Speaks Out -Apr 7 2021
-

Nobel Prize Virologist "Variants Caused by Vaccine" -May 22 2021
-

Winter Mortality Data Update -May 23 2021
-

Texas Senator Hall on why vaccine CAN NOT be mandated
-

Firefighter tests mask safety -Feb 9 2021
-

German Art Protest – Mar 20 2021
-

Dr Craig "Lockdowns Don't Work" -May 18 2021
-

Australia to Force Vaccinations -May 18 2021
-

My Mum had the Vaccine -May 19 2021
-

Mumbai, India All is Normal -May 20 2021
-

USA Kids to be Vaccinated Without Parental Consent -May 20 2021
-

Blood Shortage as Vaccinated Cannot Donate -May 2021
-

Little Girl Defends Freedom -May 20 2021
-

US Health & Safety makes employers liable for Vaccine Injuries -May 20 2021
-

Six More Years, maybe longer -Feb 11 2021
-

30-50% have Pre-Existing Immunity –Mar 11 2021
-

2009 Swine Flu Pandemic -Apr 1 2021
-

A Funeral for Democracy –Mar 7 2021
-

Vaccine is a Genetic Experiment –Mar 8 2021
-

V Sharav on K Schwab & the Nazis -Mar 19 2021
-

Anne Widdecombe on Defending Free Speech -Feb 9 2021
-

Anyone Ever Tested Positive is Counted as Covid Death -Feb 22 2021
-

Polish PM Vows to Defend Free Speech -Jan 12 2021
-

Charles Walker Mocks Health Passport -Apr 19 2021
-

Austria Chancellor "Vaccines Won't Return Liberty" –Mar 12 2021
-

New Normal Baby Delivered in Plastic Bag -Mar 25 2021
-

10 Year Old on Mask Logic -May 12 2021
-

China's Social Credit System: Digital Slavery? -May 1 2019
-

"Build Back Better" Compilation -May 19 2021
-

American Patriot VS Corona Dictators - May 14 2021
-

Dr Kaufman "On Asymptomatic Carriers" -Feb 9 2021
-

No Epidemic ever Driven by Asymptomatic Carriers -Jan 28 2020
-

"Police for Freedom" protest in The Netherlands -May 9 2021
-

Woman Paralyzed After Pfizer Vaccine -Apr 25 2021
-

Who is WHO director -May 9 2021
-

Barcelona Celebrates End to Curfews -May 9 2021
-

Science is Based on Challenge of Ideas -May 9 2021
-

Preachers Arrested for Preaching -May 9 2021
-

"We need to let Kids be Kids" -May 12 2021
-

Dr Schmidt-Krüger "The tale of the Rat" - Jan 29 2021
-

Pfizer Vaccine kills Granny! -May 7 2021
-

Sesame Street Vaccine Propaganda -May 7 2021
-

Accuracy of Covid Death Numbers -May 7 2021
-

What is a Covid19 Death -May 7 2021
-

Chef Tonia Buxton Questions Fear Agenda -May 6 2021
-

Prof Bhakdi taught this for 40 Years -May 2 2021
-

Dr Craig on Asymptomatic Transmission -Dec 8 2020
-

Asymptomatic Transmission "No Scientific Basis" -May 5 2021
-

India Crematoriums: Overwhelmed or Not? -May 4 2021
-

Prof Sikora "Pandemic is Over" -May 4 2021
-

Luxembourg Song Protest "Liberte" -May 4 2021
-

Warning from Israel "Fight the Green Pass!" -May 4 2021
-

Arizona Parents Unite to Remove Masks in Schools -Apr 28 2021
-

Dr Salmon Questions the Label "Expert" -Apr 29 2021
-

Mask causes LACK of Oxygen -Apr 27 2021
-

Nandy: Vaccines Won't End Lockdowns -Apr 28 2021
-

Human Rights Attorney on Informed Consent -Apr 27 2021
-

Doctors on New CDC Death Guidelines -Apr 27 2021
-

Funeral Home Director says "Keep Questioning" -Apr 26 2021
-

Experts say Covid Test is Unreliable -Mar 28 2021
-

Royal Hospital In Glouchester UK Completely Empty -Dec 29 2020
-

Prof Bhakdi Vaccine Benefits & Risks -Mar 29 2021
-

Indian Actor Mansoor Ali Khan protests Vaccines -Apr 20 2021
-

Prof Bhattacharya, "Fauci Blind to Lockdown Damages" -Apr 16 2021
-

Prof Gupta "Lockdowns Departed from Accepted Science" -Apr 19 2021
-

Prof Sridhar "Year of the Variant" -Apr 19 2021
-

Pub Owner to Keir Starmer "You Failed This Country!"-Apr 19 2021
-

Teen Fears for Her Generations' Future -Apr 18 2021
-

"the "Build, Back, Better" conspiracy -Jan 19 2021
-

"I Don't Need Advice how to live My Life" -Apr 14 2021
-

Dutch Police Attack Protesters -Feb 5 2021
-

Dr Giesecke on Lockdown & Vaccines -Sept 23 2020
-

Dr Schiffmann on Children Dying -Mar 1 2021
-

A Social Conditioning Experiment -Apr 17 2021
-

New York to Change Covid Death Status Retroactively -Apr 14 2021
-

NHS Vaccine Whistleblower p1 -Apr 15 2021
-

Song Protest "We don't Need No Vaccination" -Apr 14 2021
-

New Normal Ethics & Medical Tyranny -Apr 14 2021
-

CNN director on Covid Fear & Ratings -Apr 14 2021
-

Texas Normal & No Epidemic -Apr 15 2021
-

Dr McCloskey "There is Nothing Unusual" -Feb 3 2021
-

Dr Malthouse "the Real Virus is Fear" –Mar 10 2021
-

Vaccine Deaths Compilation -Apr 18 2021
-

Dr Heneghan on PCR test flaws –Mar 10 2021
-

Dr Fauci "No Reason for Me" –Mar 15 2021
-

Lawyer "We Won't Turn Schools into Vax Centres" -Apr 14 2021
-

Dr Cahill on Virus & Personal Attacks -Feb 10 2021
-

Police Chief "Don't be a Sheep" -Feb 22 2021
-

"Don’t question, just get injected" –Mar 18 2021
-

"Covid-Zero is Britain-Zero" -Feb 12 2021
-

"Do you Believe in Covid?" -Mar 28 2021
-

DeSantis "Lockdowns Don't Work" -Jan 31 2021
-

Russel Brand on Experts -May 11 2021
-

Doctors endorse smoking -1960s
-

Curfew for Men –Mar 13 2021
-

Covid Misattribution of Death –Mar 13 2021
-

Prof Livermore says Vaccine Pass not needed -Apr 8 2021
-

"Vaccine passports" must be stopped! -Apr 5 2021
-

Harvard Prof Vaccine Passports not needed -Apr 8 2021
-

Coercion is illegal use of force -Apr 3 2021
-

Citizens stand up to Police –Mar 8 2021
-

Churchill on Freedom of Speech & Thought -1949
-

China Social Credit Sytem "pushes you to be a better citizen" -Feb 7 2021
-

Boris Johnson cancels Christmas -Dec 2020
-

Bryce Mitchell We didn't vote for that - Nov 2, 2020
-

Boris Johnson Lies –Mar 8 2021
-

Bill Gates Conflict of Interest -Feb 22 2021
-

Fauci Gaslighting Us Again - Aug 26 2022
-

Germans struggle: energy crisis - July 2 2022
-

V@x or Transgenetic Therapy -Oct 14 2021
-

One World WEF Government -Feb 20 2022
-

BBC Unvaxxed Nurse Interview - Jan 12 2022
-

Adverse Reaction 743 - Dec 26 2021
-

Macron's Comments INSANE -Jan 6 2022
-

Influenza and PCR - Jan 2 2022
-

Massive Amsterdam Protest-Jan 2 2022
-

Brazilian Journalist Collapses - Jan 5 2022
-

Omicron reaction unjustified - Dec 1 2021
-

"Heavily Mutated" Variant - Nov 28 2021
-

Malcolm Roberts global governance - Nov 28 2021
-

Zuckerberg: Vaccine Changes DNA - Nov 27 2021
-

UK Column News Banned from Youtube -May 31 2021
-

The Liverpool Test for Covid - Sept 2020
-

Del Bigtree on Vaccine Risks -Apr 25 2021
-

Dr. Fiechtner Slams Endless Propaganda -Jan 18 2021
-

Dr. Fiechtner "Constitutionally Citizens have the Right to Resist" -Jan 18 2021
-

Banned World Freedom Rally vid -Apr 20 2021
-

Bhakdi, Vax Use Must Stop -Feb 19 2022
-

Vaccines Fundamentally Flawed Pt. 2 -Nov 27 2021
-

Vaccines Fundamentally Flawed Pt. 1 -Nov 27 2021
-

Prof Bhakdi Destroys Covid Myths -Aug 8 2021
-

Professor Bhakdi on Vaccines & Pregnancy -June 12 2021
-

Professor Bhakdi on Vax Dangers to Ovaries & Placenta -June 11 2021
-

Prof Bakhdi "Zero Science" –Mar 18 2021
-

Prof Bhakdi taught this for 40 Years -May 2 2021
-

Prof Bhakdi Vaccine Benefits & Risks -Mar 29 2021
-

Prof Bhakdi on Test Cycle Threshold -Apr 20 2021
-

Baby Injections - Sep 9 2023
-

Myocarditis Increase in Young People -Aug 23 2023
-

UK Abhorrent Deaths Double Standard -Aug 18 2023
-

Prof. Fenton MHRA Hiding Vax Safety Signal -Aug 7 2023
-

Parents Who Don't Vaccinate -Apr 1 2023
-

Dr John UK Vaxing Kids -Jan 25 2023
-

Cardiac Events Spike Post Vax -Nov 22 2022
-

Taking Boosters, All Roads Lead to Covid! -Oct 20 2022
-

Swiss Study, Vaccine induced Myocarditis -Oct 20 2022
-

Unvaxxed Kids Don't Get Sick -Oct 10 2022
-

N Wolf, Placenta Damage Pt. 1 -Sep 2 2022
-

Funeral Director John O'Looney Update - Jul 25 2022
-

Pfizer Kid Trial - Aug 28 2022
-

Shocking Pfizer Fraud Kids Vaccine Trial -Aug 8 2022
-

The Most Radical Experiment in Human History -Jul 24 2022
-

Vaccine Deaths, Bild TV Debate -May 11 2022
-

15 Year-old Pfizer Damaged -May 12 2022
-

Make the Children Feel Guilty - Mar 26 2022
-

Student's Mock Thank You - Jan 22 2022
-

10yr Old Chilean Vax Death -Jan 15 2022
-

946K Injuries or Death - Jan 6 2022
-

British Normalize Kid Heart Attack-Jan 4 2022
-

Why Pfizer Must Inject Kids -Dec 29 2021
-

WHO: Boosters to kill children - Dec 27 2021
-

India Vaccination for Kids -Dec 26 2021
-

Young People Dropping from Pfizer -Dec 16 2021
-

Pfizer Kids All Risk No Benefit -Dec16 2021
-

Don't Pass Fight Onto Kids - Dec 15 2021
-

LA Parents Celebrate - Dec 15 2021
-

Malone: Don't Vaccinate Kids -Dec 14 2021
-

LA Kids Vaccinated No Consent - Dec 14 2021
-

Cover Me With Sunshine -Dec 12 2021
-

Unvaxxed children ritually humiliated - Dec 12 2021
-

Pfizer Vax ,Child Deaths -Dec 7 2021
-

Tenpenny: tsunami of deaths - Nov 26 2021
-

Tenpenny: millions of children - Dec 3 2021
-

Kids & Masks: Protect Kids - Nov 17 2021
-

Daughter's Vaccine Injuries - Nov 29 2021
-

Chris Whitty Murderer! -Nov 25 2021
-

Do Not Give Vaccine to Kids - Nov 24 2021
-

Saline replaced with Tromethamine - Nov 13 2021
-

Adelaide Care Workers Protest -Nov 8 2021
-

Kids Dying from V@x -Oct 29 2021
-

NY Protests de Blasio -Oct 28 2021
-

FDA Vax Decision 5-11yr Olds -Oct 26 2021
-

V@x & Fetal Damages/Deaths -Oct 1 2021
-

Ex Police Officer Speaks -Sep 12 2021
-

Vaxxer vs Truther rap battle UK - Oct 11 2021
-

Vax not intended for kids - Mar 2021
-

Fauci vs Sen. Paul on kids vax - Oct 10/11 2021
-

Bill Gates, Vaccinating Kids -Sep 23 2021
-

Covid Death Figures -Sept 30 2021
-

Justin Hart Covid Death Risks -Sept 21 2021
-

Pfizer Vax for 5-11 -Sept 21 2021
-

Stop! Not Enough Data -Sept 19 2021
-

Doctors For Truth -Sept 16 2021
-

Mall Protest -Sept 13 2021
-

Scotland Removes Parental Rights -Sept 14 2021
-

Athlete After the Jab -Sept 11 2021
-

Mother: Don't Vax Your Kids! -Aug 15 2021
-

Dr Tyson "Kids Die From Vax" -July 30 2021
-

College Athletes & Vax Injury -July 28 2021
-

Ilana Rachel Daniel on Vax in Israel -July 23 2021
-

Dr Saphier on Vaccine Logic -July 8 2021
-

Dr Tyson on Ivermectin & HCQ -July 1 2021
-

Dr McCullough "Vaccine Dangerous for Kids" -June 2 2021
-

Dr Gold on the Legality of Vaccinating Kids -May 28 2021
-

Dr McCullough Vaccine Injury Data -June 4 2021
-

Hancock Stumbles as he says "Vax not for Children" -Nov 10 2020
-

Vaccine & Heart Problems in Teens -May 24 2021
-

Vaccines & Teen Heart Attacks -May 25 2021
-

Vaccine & Heart Problems -May 25 2021
-

Children Are Dying from the Vaccine -May 22 2021
-

Ron Paul "Why This Push To Vaccinate Kids" -May 5 2021
-

MSM Push to get Kids Vaccinated -May 16 2021
-

Fauci "Kids Are Next" –Mar 17 2021
-

USA Kids to be Vaccinated Without Parental Consent -May 20 2021
-

Sesame Street Vaccine Propaganda -May 7 2021
-

Vaccine Trials on Kids -Apr 15 2021
-

CA legal attorney says "We will not turn our schools into vaccination centres"










